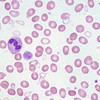
هیستوگرام، RBC، هماتولوژی، خونشناسی

جزوه هماتولوژی - دکتر پوپک جلد 1
جزوه هماتولوژی دکتر پوپک
جلد اول
فایل PDF- زبان فارسی
424 صفحه
۱۱۹٫۰۰۰تومان
۱۱۹٫۰۰۰
سوالات پرتکرار
آیا برای خرید لازم است از قبل در وبسایت ثبتنام کرده باشم؟
خیر، شما با انتخاب و اضافه کردن محصولات به سبد خریدتان میتوانید اطلاعات فردی و ارسالتان را کامل کنید و پرداخت را انجام دهید.
چطور هزینه سفارش را پرداخت کنم؟
تمامی کاربران میتوانند از طریق درگاه بانکی با تمام کارتهای عضو شتاب هزینه سفارش را به صورت اینترنتی پرداخت نمایند.
چه طور فایل خریداری شده بدستم میرسد؟
بلافاصله پس از پرداخت مبلغ ، فایل به آدرس ایمیلی که در هنگام ثبت مشخصات اعلام کرده اید ، ارسال میشود.